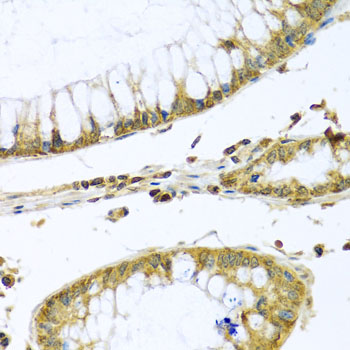
Immunohistochemistry - PMPCB Polyclonal Antibody

-
Product Name
PMPCB Polyclonal Antibody
- Documents
-
Description
Polyclonal antibody to PMPCB
-
Tested applications
WB, IHC
-
Species reactivity
Human, Mouse, Rat
-
Alternative names
PMPCB antibody; Beta-MPP antibody; MPP11 antibody; MPPB antibody; MPPP52 antibody; P-52 antibody; mitochondrial-processing peptidase subunit beta antibody
-
Isotype
Rabbit IgG
-
Preparation
Antigen: Recombinant fusion protein containing a sequence corresponding to amino acids 110-380 of human PMPCB (NP_004270.2).
-
Clonality
Polyclonal
-
Formulation
PBS with 0.02% sodium azide, 50% glycerol, pH7.3.
-
Storage instructions
Store at -20℃. Avoid freeze / thaw cycles.
-
Applications
WB 1:500 - 1:2000
IHC 1:50 - 1:200 -
Validations

Western blot - PMPCB Polyclonal Antibody
Western blot analysis of extracts of various cell lines, using PMPCB antibody at 1:1000 dilution.Secondary antibody: HRP Goat Anti-Rabbit IgG (H+L) at 1:10000 dilution.Lysates/proteins: 25ug per lane.Blocking buffer: 3% nonfat dry milk in TBST.Detection: ECL Basic Kit .Exposure time: 90s.

Immunohistochemistry - PMPCB Polyclonal Antibody
Immunohistochemistry of paraffin-embedded human stomach using PMPCB antibody at dilution of 1:100 (40x lens).

Immunohistochemistry - PMPCB Polyclonal Antibody
Immunohistochemistry of paraffin-embedded rat kidney using PMPCB antibody at dilution of 1:100 (40x lens).
Immunohistochemistry - PMPCB Polyclonal Antibody
Immunohistochemistry of paraffin-embedded human colon carcinoma using PMPCB antibody at dilution of 1:100 (40x lens).
-
Background
Catalytic subunit of the essential mitochondrial processing protease (MPP), which is required for maturation of the majority of mitochondrial precursor proteins. Most MPP cleavage sites follow an arginine at position -2 (By similarity).
Related Products / Services
Please note: All products are "FOR RESEARCH USE ONLY AND ARE NOT INTENDED FOR DIAGNOSTIC OR THERAPEUTIC USE"
